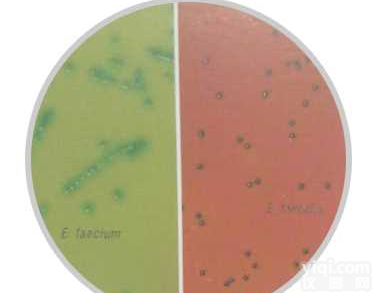
<em>显色</em><em>培养基</em>屎肠<em>球菌</em>

抗万古霉素肠球菌显色培养基干粉 法国科玛嘉显色培养基
- 品牌:法国科玛嘉
- 产地:法国科玛嘉CHROMagar
- 供应商:上海桥星贸易有限公司
- 供应商报价:面议
- 标签:抗万古霉素肠球菌显色培养基干粉 法国科玛嘉显色培养基,1500,上海桥星贸易有限公司
抗万古霉素肠球菌显色培养基干粉 法国科玛嘉显色培养基 原装,质量保证,现货供应
规格:1L
抗万古霉素肠球菌显色培养基干粉 法国科玛嘉显色培养基 产品详细介绍:
产品用途
用于抗万古霉素肠球菌(VRE)的检测
组 分
科玛嘉抗万古霉素肠球菌(VRE)基础培养基和增补剂各一瓶。
基础培养基:琼脂:15.0 g/L 蛋白胨和酵母粉:20.0 g/L 氯化钠:5.0g/L 色素:27.3 g/L
增 补 剂:0.06 g/L
pH值:6.9±0.2
操 作
1、基础培养基:取瓶内干粉67.3 g溶于1000 mL去离子水的洁净三角瓶中,充分搅拌混匀。也可根据需要按照67.3 g/L的比例扩大或缩小制备培养基的量。
2、加热至100℃,不停搅拌,使其完全溶解。切勿加热超过100℃,切勿121℃高压灭菌。若使用微波炉加热,应将培养基加热沸腾,立即移出,轻轻摇匀,再放入微波炉加热,观察小气泡变为大气泡,直至完全溶解即可。切勿使培养基溢出。
3、增补剂:取增补剂0.06g溶于1mL50% 酒精溶液(0.5mL无水乙醇+0.5mL无菌水)中,搅拌混匀。也可按照60mg/L的比例扩大或缩小制备增补剂的量。增补剂需现配现用,配制好的增补剂在-20℃下保存,有效期为一个月。
4、把混匀后的增补剂加入到冷却至45℃~50℃的基础培养基中(增补剂的终浓度为60mg/L),轻轻摇动使其充分混匀,倾注平皿,使其凝固,晾干备用。
保存
该成品平板在室温可保存一天或在冰箱内贮存1个月(2℃~8℃,避光)。
质量控制
1、外观
此干粉培养基的粉末均匀,具有良好的流动性,呈淡黄色。制备好的培养基平板为淡黄色透明固体。
2、微生物实验
接种以下菌株于该培养基平板上,在36±1℃恒温条件下有氧培养18-24h。
| 质控菌株 | 菌落颜色 |
| 抗万古霉素肠球菌(VRE)ATCC51299 | 淡紫色,小菌落 |
| 粪肠球菌ATCC29212 | YZ |
| 大肠杆菌ATCC25922 | YZ |
| 热带假丝酵母ATCC1369 | YZ |
| 金黄色葡萄球菌ATCC25923 | YZ |
| 铅黄链球菌ATCC700327 | YZ |
| 鸡肠球菌ATCC49573 | YZ |
性能及局限
Z终鉴定需要做补充试验。一些乳酸杆菌、片球菌可能会出现淡紫色菌落,可通过PYR(吡咯烷酮芳基酰胺酶)试验进行排除,PYR结果为阳性的是VRE,PYR结果为阴性的是乳酸杆菌、片球菌。培养时间超过24h后,一些罕见的鹑鸡肠球菌可能出现淡紫色菌落。
贮存条件
基础培养基和增补剂均贮存于15℃~30℃干燥环境中,在有效期前使用。
污染处理
使用过的培养基需要在121℃灭菌至少20分钟才可以按照有关规定丢弃。
抗万古霉素肠球菌显色培养基干粉 法国科玛嘉显色培养基 相关产品列表:
| 产品 | 价格 |
| 念珠菌显色培养基1L | 760 |
| 定位显色培养基1L | 600 |
| 大肠杆菌显色培养基1L | 600 |
| ECC显色培养基1L | 600 |
| 沙门氏菌显色培养基1L | 600 |
| 金葡菌显色培养基500mL | 560 |
| 耐甲氧西林金黄色葡萄球菌MRSA显色培养基1L | 1500 |
| 沙门氏+菌显色培养基1L | 1100 |
| O157显色培养基1L | 630 |
| 改良0157显色培养基1L | 660 |
| 李斯特菌显色培养基1L | 1100 |
| 弧菌显色培养基1L | 1000 |
| 假单胞显色培养基1L | 1100 |
| B族链球菌显色培养基1L | 1500 |
| 阪崎肠杆菌显色培养基1L | 760 |
| 抗万古霉素肠球菌VRE显色培养基1L | 1500 |
| ESBL显色培养基1L | 1500 |
| KPC显色培养基1L | 1500 |
| 李斯特菌鉴定显色培养基250mL | 2200 |
| CTX-M显色培养基1L | 1500 |
| 马拉瑟菌显色培养基1L | 1500 |
| 不动杆菌显色培养基1L | 1500 |
| STEC显色培养基1L | 1500 |
| 志贺氏菌显色培养基1L | 880 |
| 蜡样芽孢杆菌显色培养基1L | 1200 |
| 尿路菌群显色培养基1L | 600 |